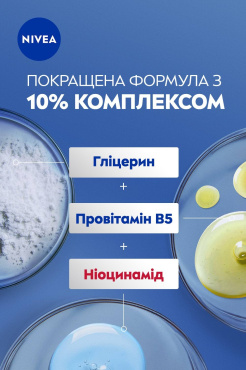
Лосьйон для тіла NIVEA Відновлення та догляд 250 мл фото 4

Лосьйон для тіла NIVEA Відновлення та догляд 250 мл
Обмін/повернення товару належної якості протягом 14 днів.
Характеристики
| Країна-виготовлення товару | Іспанія |
|---|---|
| Brand | NIVEA |
| Об'єм | 250 мл |
| Клас косметики | Мас маркет |
| Тип шкіри | Суха |
| Призначення | Живлення; Зволоження |
| Час застосування | Універсальні |
Опис Лосьйон для тіла NIVEA Відновлення та догляд 250 мл
Для кого цей продукт
Лосьйон для тіла SOS від NIVEA Відновлення та догляд 250 мл підходить для тих, хто стикається з сухістю, стягнутістю та подразненням шкіри. Це вибір для тих, хто хоче швидко повернути комфорт та м'якість шкірі тіла щодня.
Ключові переваги
- Інтенсивно зволожує та заспокоює шкіру вже після першого застосування
- Відновлює природний бар’єр шкіри
- Легка текстура, швидко вбирається, не залишає липкості
- Підходить для чутливої та дуже сухої шкіри
- Зручний об’єм – 250 мл для щоденного використання
Спробуйте зараз та відчуйте різницю!
Вам потрібне рішення для сухої шкіри?
Ваша шкіра стягується чи лущиться після душу? Потрібно швидко повернути їй відчуття комфорту? Лосьйон для тіла SOS від NIVEA створений саме для цього. Він допоможе, коли навіть звичайний крем не дає результату. Якщо прагнете, щоб тіло було доглянутим і гладким – це рішення для вас.
Як це працює?
Лосьйон містить активні інгредієнти, які проникають у глибокі шари шкіри. Вони інтенсивно зволожують, допомагають відновити захисний бар’єр та утримують вологу всередині. Засіб має легку консистенцію, швидко вбирається та не залишає відчуття жирності. Регулярне використання повертає шкірі м’якість, еластичність та здоровий вигляд.
Спосіб застосування
Нанесіть невелику кількість лосьйону на чисту суху шкіру тіла легкими масажними рухами. Використовуйте щодня, особливо після душу або ванни. Для досягнення найкращого результату звертайте увагу на дуже сухі ділянки шкіри.
Склад
Спосіб застосування
Відгуки Лосьйон для тіла NIVEA Відновлення та догляд 250 мл
Найкращі відгуки покупців
Немає відгуків